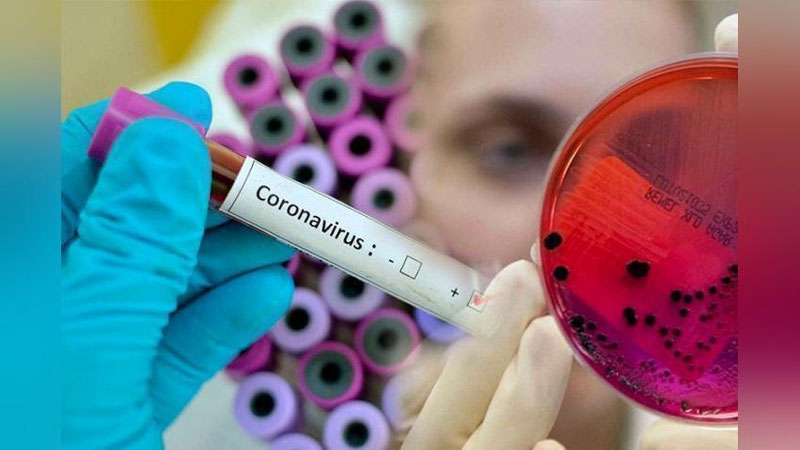

Bu xaqda "Euronews" xabar bermoqda. Koronavirus pandemiyasi tufayli, Portugaliyaning 45 ta munisipaliteti, shu jumladan Lissabon va Algarve kurortida tungi komendant soatlari joriy etilgan. Ushbu chora mamlakat aholisining deyarli yarmiga ta`sir qiladi. Portugaliyada Delta shtamm faol ravishda tarqalmoqda, buni yuqtirganlar 55% dan ortiqni tashkil qiladi. Hukumat vaziyat yomonlashayotganini aytmoqda.
Evropa Ittifoqi aholisining yarmi koronavirusga qarshi emlashning birinchi dozasini allaqachon olgan. Ba`zi mamlakatlarda o`spirinlarni emlash boshlandi. Daniyada 12 yoshdan 15 yoshgacha bo`lgan bolalar 19 iyuldan boshlab emlash uchun ariza berishlari mumkin, ammo ba`zi pediatrlar boshqa mamlakatlarning tadqiqot natijalarini olish uchun 2 oy kutishga chaqirishmoqda.
«Vaktsinasiya qilingan bolalar soni kamligi sababli hali xabar qilinmagan alomatlar keyinroq paydo bo`lishi mumkinligidan xavotirdaman. Biz ko`proq kutishimiz kerak, shu asosda biz bolalar va ularning ota-onalarini professional darajada xabardor qilishimiz mumkin bo`ladi », - tushuntiradi Danske Bornelger pediatriya assosiasiyasi rahbari Klaus Birkeland Yoxansen.
Rossiya Federasiyasida Covid-19 kasalligining kunlik o`sishi yanvar oyining o`rtalaridan beri maksimal darajaga etgani ma`lum qilinmoqda. 24 439 kishi virus yuqtirgan, 697 bemor vafot etgan.